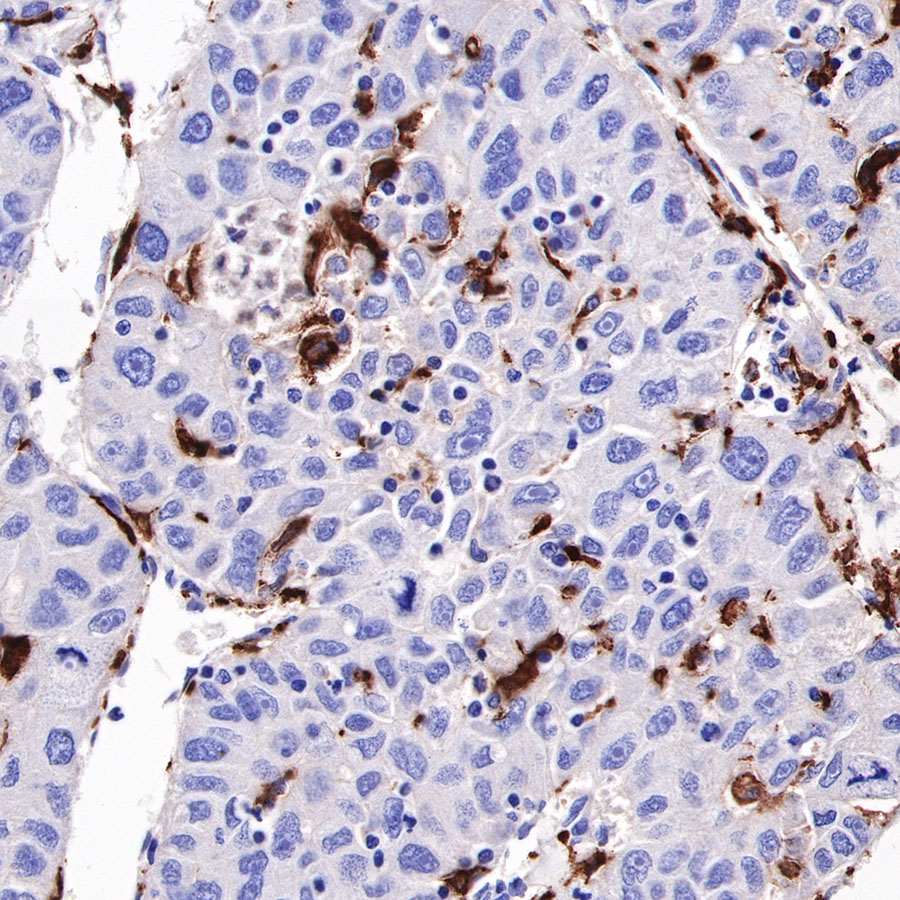

Product Specification
| Host |
Rabbit |
| Antigen |
CD163 |
| Synonyms |
M130, Hemoglobin scavenger receptor |
| Immunogen |
N/A |
| Location |
Secreted, Cell membrane |
| Accession |
Q86VB7 |
| Clone Number |
SDT-R164 |
| Antibody Type |
Recombinant mAb |
| Application |
WB, IHC-P, IP, IF |
| Reactivity |
Hu, Ms, Rt |
| Purification |
Protein A |
| Concentration |
0.25 mg/ml |
| Tag |
N/A |
| Physical Appearance |
Liquid |
| Storage Buffer |
PBS, 40% Glycerol, 0.05% BSA, 0.03% Proclin 300 |
| Stability & Storage |
12 months from date of receipt / reconstitution, -20 °C as supplied |
Dilution
| application |
dilution |
species |
| WB |
1:500 |
null |
| IHC-P |
1:1000-1:2000 |
null |
| IF |
1:2000 |
null |
| IP |
1:25 |
null |
Background
CD163 is a monocyte/macrophage specific marker expressed predominantly on cells which possess strong anti-inflammatory potential. The expression of CD163 is strongly induced by anti-inflammatory mediators such as glucocorticoids and interleukin-10, while being inhibited by pro-inflammatory mediators such as interferon-gamma. CD163-expressing mononuclear phagocytes, as well as soluble CD163, may both take part in downregulating an inflammatory response [PubMed: 22038213].